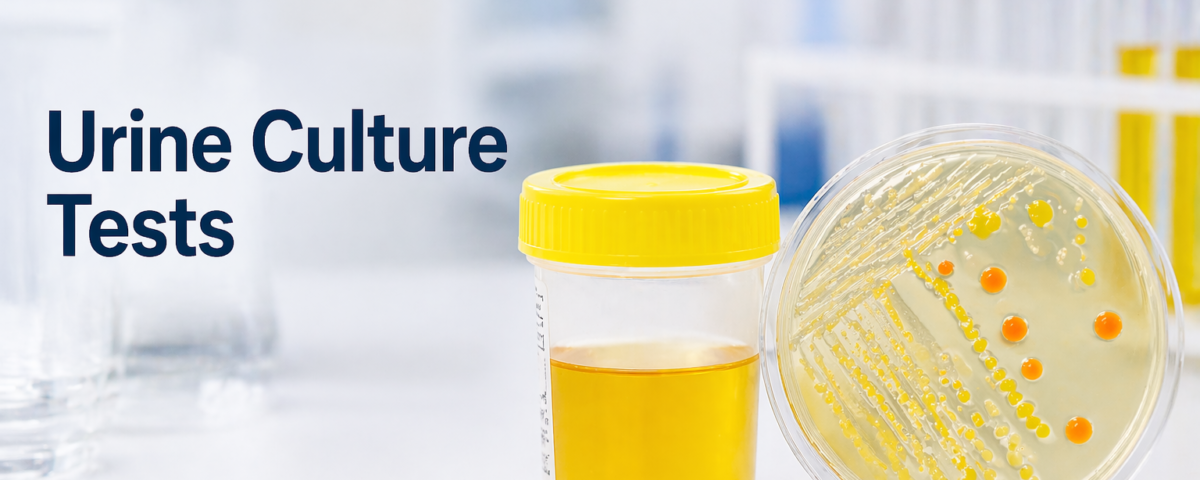

Why Urine Culture Tests Are Essential for Accurate Diagnosis and Better Health

Why Choose Trutest for Blood Test Home Collection in Gurgaon?
April 22, 2026
Know Your Lipid Profile: The First Step Toward a Healthy Heart
April 27, 2026Why Urine Culture Tests Are Essential for Accurate Diagnosis and Better Health is a topic that deserves attention because urinary infections and related conditions are very common yet often misunderstood. A urine culture test plays a crucial role in identifying infections in the urinary tract and helps doctors provide the right treatment at the right time. Many people rely only on basic urine tests, but a urine culture test goes a step further by detecting the exact bacteria or microorganisms causing the infection. This ensures accurate diagnosis and prevents complications that can affect overall health.
For those seeking reliable diagnostic services, opting for a urine culture test in gurgaon can help ensure timely detection and accurate results, leading to effective treatment and better overall health outcomes.

What is a Urine Culture Test
A urine culture test is a laboratory test used to detect bacteria, fungi, or other microorganisms present in urine. Unlike routine urine analysis, which checks general parameters, a urine culture test specifically identifies the type of infection and its severity.
The process usually involves:
- Collecting a clean urine sample
- Placing the sample in a culture medium
- Allowing microorganisms to grow
- Identifying the organism and testing antibiotic sensitivity
This detailed approach makes the urine culture test highly reliable for diagnosing urinary tract infections and related conditions.
Importance of Accurate Diagnosis
Accurate diagnosis is the foundation of effective treatment. A urine culture test helps eliminate guesswork by identifying the exact cause of infection. Without this test, doctors may prescribe antibiotics based on assumptions, which can lead to ineffective treatment.
Some key benefits of accurate diagnosis include:
- Targeted treatment based on the specific bacteria
- Faster recovery and reduced symptoms
- Prevention of recurring infections
- Reduced risk of antibiotic resistance
A urine culture test ensures that the treatment plan is precise and tailored to the patient’s condition.
Detecting Urinary Tract Infections Early
Urinary tract infections can affect different parts of the urinary system, including the bladder, kidneys, and urethra. Early detection is important to prevent the infection from spreading.
A urine culture test helps in:
- Confirming the presence of infection
- Identifying whether it is bacterial or fungal
- Determining the severity of the infection
Common symptoms that may require a urine culture test include:
- Burning sensation during urination
- Frequent urge to urinate
- Cloudy or foul-smelling urine
- Lower abdominal pain
By using a urine culture test, healthcare providers can diagnose the problem early and start appropriate treatment.
Guiding Effective Treatment
One of the most important roles of a urine culture test is guiding treatment decisions. After identifying the bacteria, the test also shows which antibiotics will work best against it.
This process is known as sensitivity testing and helps in:
- Choosing the most effective medication
- Avoiding unnecessary or incorrect antibiotics
- Reducing treatment duration
- Improving patient outcomes
Without a urine culture test, treatment may not be as effective, and the infection may persist or worsen.
Preventing Complications
Untreated or improperly treated urinary infections can lead to serious health issues. A urine culture test helps prevent these complications by ensuring timely and accurate treatment.
Possible complications include:
- Kidney infections
- Chronic urinary problems
- Spread of infection to the bloodstream
- Increased risk for pregnant women and elderly patients
By relying on a urine culture test, doctors can prevent these risks and maintain better health outcomes.

Role in Recurrent Infections
Some individuals experience repeated urinary infections. In such cases, a urine culture test becomes even more important. It helps identify whether the infection is caused by the same bacteria or different strains.
Benefits in recurrent cases include:
- Understanding the root cause of repeated infections
- Detecting antibiotic resistance
- Adjusting long-term treatment plans
- Preventing further recurrence
A urine culture test is essential for managing chronic or recurring urinary conditions effectively.
Importance for Special Groups
.Certain groups of people require extra attention when it comes to urinary health. A urine culture test is especially important for:
- Pregnant women, to prevent complications during pregnancy
- Children, where symptoms may not be clear
- Elderly individuals, who may have weakened immunity
- Patients with diabetes, who are more prone to infections
In these cases, a urine culture test ensures early detection and proper management of infections
Supporting Overall Health
Urinary health is closely connected to overall well-being. Ignoring symptoms or delaying diagnosis can affect other parts of the body. A urine culture test supports overall health by ensuring that infections are properly treated.
Key contributions to better health include:
- Maintaining kidney function
- Preventing systemic infections
- Improving quality of life
- Reducing healthcare costs in the long run
Regular use of a urine culture test when symptoms appear can help maintain a healthy lifestyle.
When Should You Take a Urine Culture Test
Knowing when to take a urine culture test is important. Doctors may recommend it in the following situations:
- Persistent urinary symptoms
- Failure of initial treatment
- Recurrent infections
- Pregnancy checkups
- Pre-surgical evaluations
Taking a urine culture test at the right time can make a significant difference in diagnosis and treatment.

Conclusion
Why Urine Culture Tests Are Essential for Accurate Diagnosis and Better Health becomes clear when we understand their role in detecting infections, guiding treatment, and preventing complications. A urine culture test is not just a routine test but a powerful diagnostic tool that ensures precise medical care. From early detection of urinary tract infections to managing recurrent conditions, the urine culture test plays a vital role in maintaining overall health. By relying on this test, patients and healthcare providers can work together to achieve better outcomes and a healthier life.
For accurate results and trusted diagnostic services, choosing the best pathology lab in gurugram is essential to ensure proper testing, timely reports, and effective treatment planning.